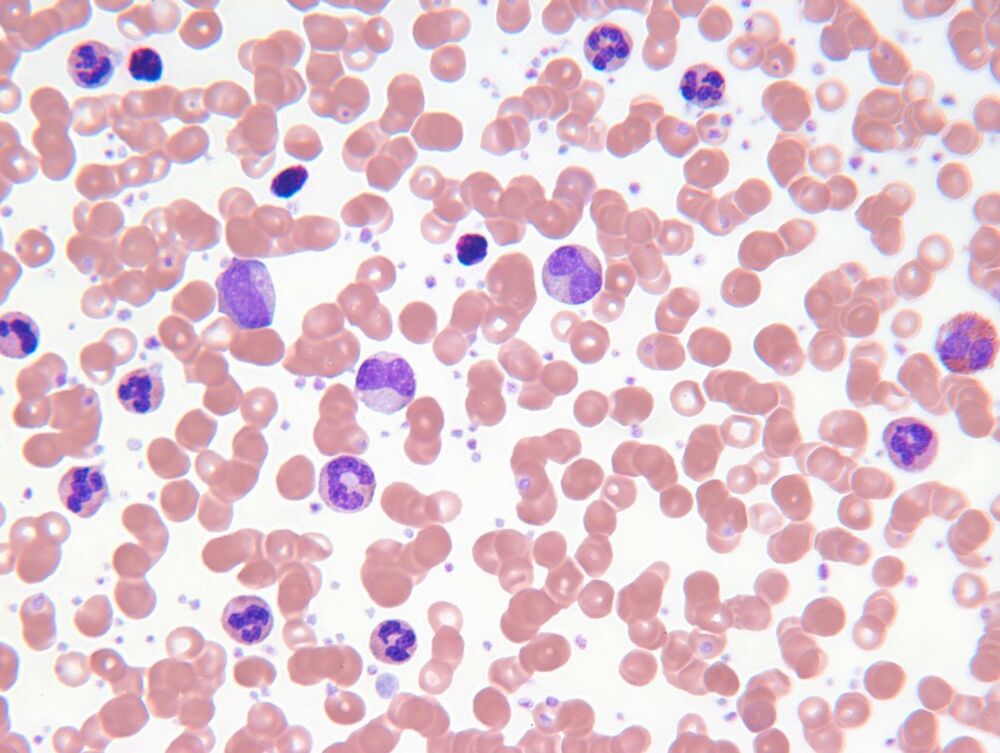
Leukemija

TUGA
OVU VRSTU LEUKEMIJE JE IMAO SINIŠA MIHAJLOVIĆ: Srpska doktorka otkrila KOJI SU KLJUČNI SIMPTOMI
Lečenje se uvek najpre počinje hemioterapijom tako što se pacijentu daju dva ili više citostatika u obliku infuzija
Preminuo je naš slavni fudbaler Siniša Mihajlović. U avgustu 2019. godine lečio se u Bolonji zbog borbe sa galopirajućom leukemijom. Nakon što se saznalo za Sinišinu borbu, ime ove bolesti postalo je najpretraživanija reč na „Guglu“ na ovim prostorima.
Kakva je to bolest, koji su njeni simptomi i kako može da se leči, rekla je za Blic Ženu pre 3 godine prof. dr Anom Vidović, hematologom iz Klinike za hematologiju Kliničkog centra Srbije.
Akutna leukemija je maligna bolest krvi koja brzo napreduje. Postoje dva glavna oblika kod odraslih – mijeloblastna i limfoblastna, a simptomi koji ukazuju na ovu bolest su konstantan umor, povišena temperatura, pojačano znojenje, znakovi krvarenja, naročito po koži.
– Akutna leukemija je maligne hematološke bolesti koje se karakterišu ubrzanim deljenjem i nagomilavanjem mladih leukemijskih ćelija u koštanoj srži, a zatim u krvi i mnogim organima, jetri, slezini, a ponekad i u centralnom nervnom sistemu. Suština poremećaja je u blokadi normalnog procesa sazrevanja ćelija krvi, koje ostaju nezrele i beskorisne, kao i u zaustavljanju procesa prirodnog umiranja ćelija, takozvanoj apoptozi – objašnjava doktorka Vidović.
Usled toga, kaže, nastaje malokrvnost, smanjenje broja trombocita, dok je broj belih krvnih ćelija najčešće povećan, kod oko 60 odsto bolesnika, ali može biti i normalan, pa i snižen. Uzroci nastanka akutnih leukemija su mnogobrojni, mada proces same geneze ove bolesti još nije u potpunosti rasvetljen.
– Zna se da jonizujuće zračenje, ranija primena citostatika, različite hemikalije koje se koriste u industriji i poljoprivredi, kao i neke imunološke bolesti imaju uticaja na nastanak leukemije. U principu, ovo nisu nasledne bolesti i spadaju u retke poremećaje, sa oko dva do šest novoobolelih na 100.000 stanovnika. Nešto su češće kod muškaraca, ali to nije statistički značajno – ističe doktorka Vidović.
Mijeloblastna leukemija najčešća kod odraslih
Postoje dva glavna oblika akutnih leukemija kod odraslih: mijeloblastna (čini oko 75 –80% svih akutnih leukemija) i limfoblastna (20 –25%).
Kod dece dominira akutna limfoblastna leukemija.
– Simptomi akutnih leukemija su prilično nespecifični: malaksalost, umor, pojačano znojenje, povišena temperatura, gušobolja i posebno pojava znakova krvarenja, naročito po koži u vidu sitnih tačkastih krvarenja, modrica ili pak slivenih krvarenja po sluznicama.
Dijagnoza se postavlja primenom tačno određenog algoritma i podrazumeva niz procedura.
– Citološkim pregledom koštane srži određuje se procenat mladih leukemijskih ćelija. Nalaz 20 odsto i više procenata ovih ćelija potvrđuje dijagnozu akutne leukemije.
Lečenje obuhvata više tretmana
Lečenje se uvek najpre počinje hemioterapijom tako što se pacijentu daju dva ili više citostatika u obliku infuzija.
– Tu je i suportivna terapija, čiji je razvoj u velikoj meri doprineo poboljšavanju rezultata lečenja primenom adekvatnih antibiotika, antimikotika, transfuzija krvnih derivata... Kod pojedinih oblika primenjuje se ciljana, target terapija, što predstavlja novi vid lečenja akutnih leukemija i, naravno, transplantacija matičnim ćelijama od podudarnog srodnog ili nesrodnog davaoca. Stopa izlečenja varira u zavisnosti od oblika akutne leukemije, uzrasta bolesnika, pridruženih bolesti…
Srbija je povezana s bankom davalaca matičnih ćelija hematopoeze od 2013, što je otvorilo put za sve vrste transplantacije u našoj zemlji. Najduže se rade na VMA, zatim u Novom Sadu, a na Klinici za hematologiji KCS od novembra 2017.
(Espreso)
Uz Espreso aplikaciju nijedna druga vam neće trebati. Instalirajte i proverite zašto!







